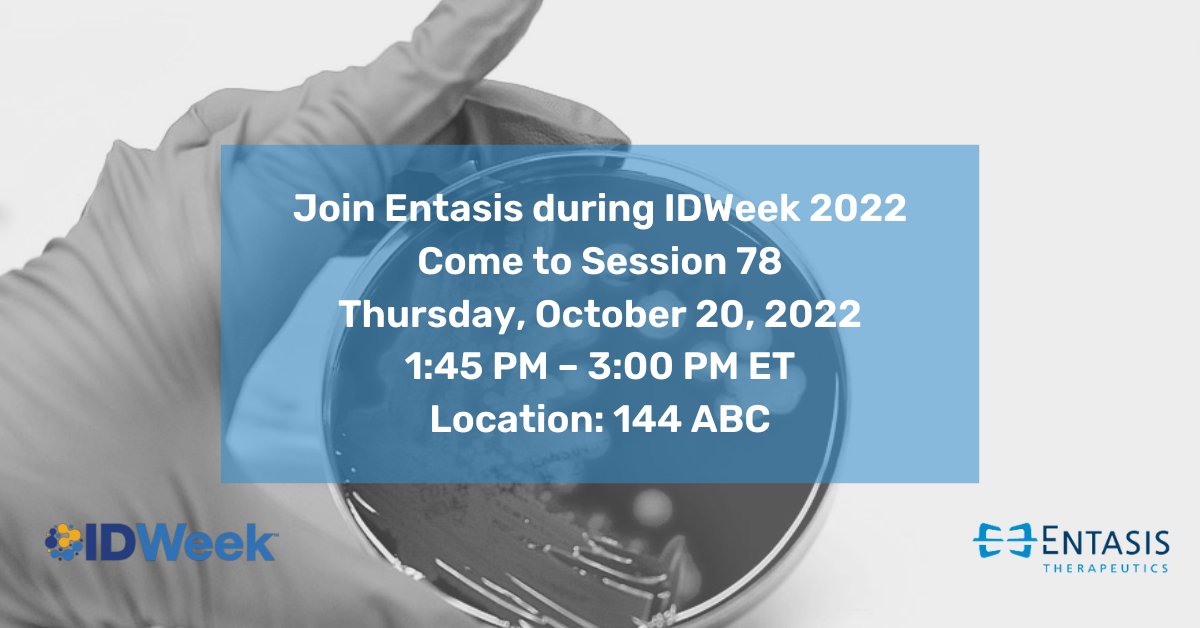
Entasis Therapeutics tweet media
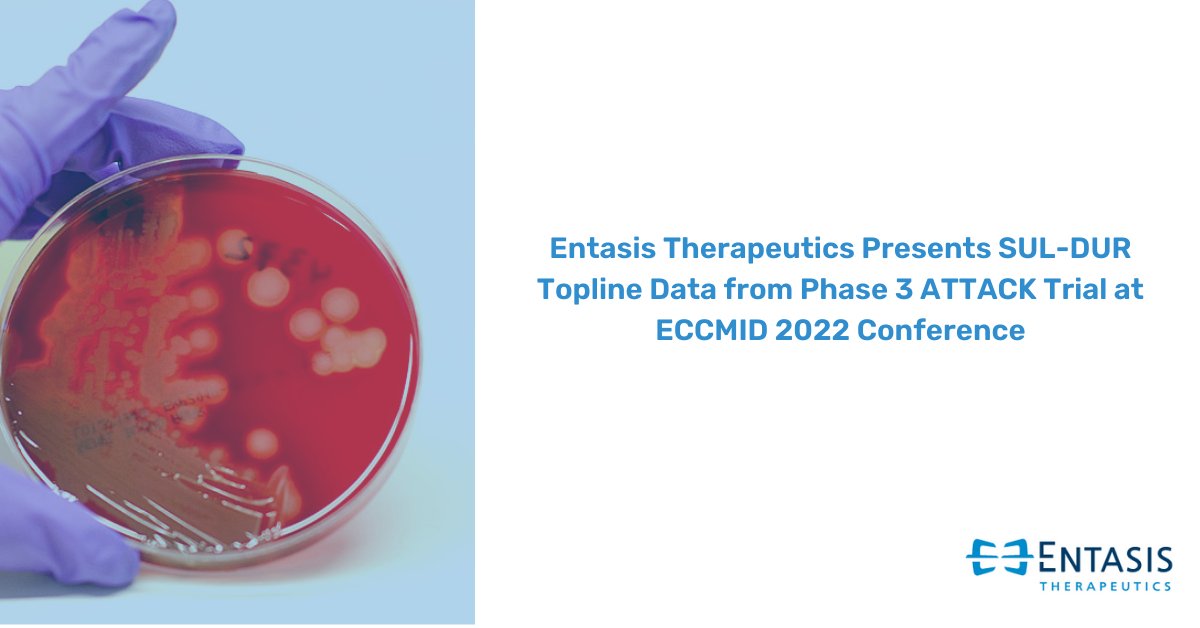
Entasis Therapeutics tweet media

We are proud to be part of biopharma Innoviva Specialty Therapeutics, a subsidiary of Innoviva Inc., delivering innovative #CriticalCare and #InfectiousDisease therapies to patients.
Follow us @innovivastx moving forward. #ISTX #MedNews
bit.ly/3ps0h4f

English